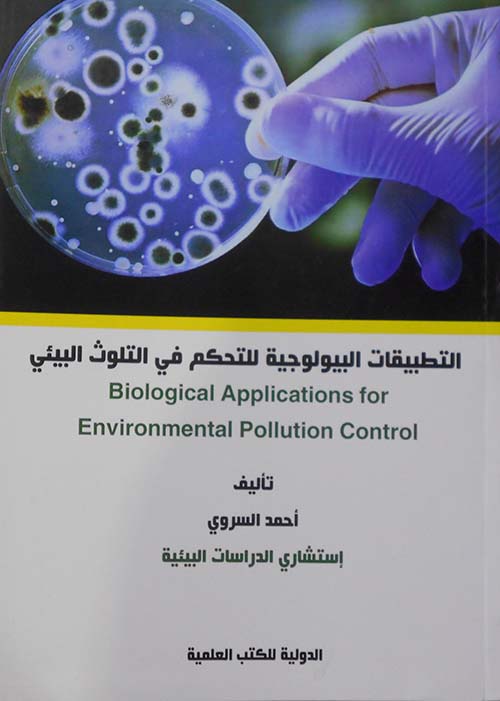

التطبيقات البيولوجية للتحكم في التلوث البيئي
الكاتب: أحمد السروي
تصنيف: العلوم و الطبيعة / بيولوجيا
الناشر: الدولية للكتب العلمية
السّنة: 2022-03-01
ردمك:
السّعر (USD): 4.0

يَوْمَ نَطْوِي السَّمَاءَ كَطَيِّ السِّجِلِّ لِلْكُتُبِ
📚 فهرس عناوين مكتبة نيل و فرات - رجب 1446/جانفي 2025الكاتب: أحمد السروي
تصنيف: العلوم و الطبيعة / بيولوجيا
الناشر: الدولية للكتب العلمية
السّنة: 2022-03-01
ردمك:
السّعر (USD): 4.0